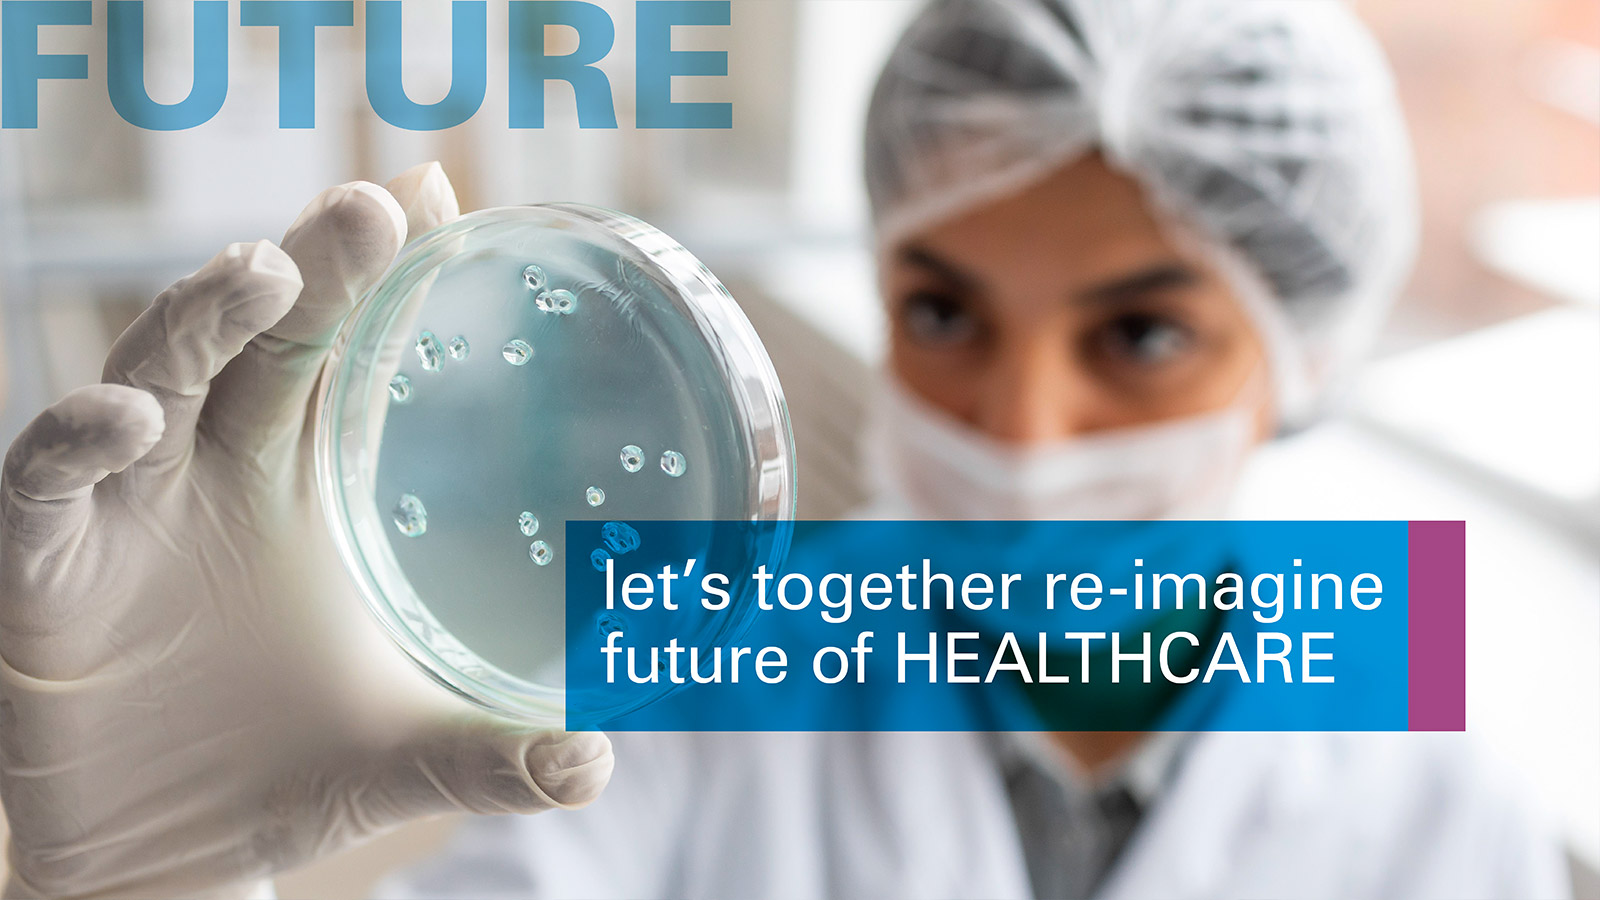

About Indian Biotics Pharma
At the forefront of research to deliver innovative healthcare solutions. At Indian Biotics Pharma , we are at the exciting intersection of science,
Our Vision
We envision a future where our contributions extend beyond traditional pharma protocols, embracing holistic approaches...
Contact Us
Indian Biotics Pharma
No 24, Katha No 47/24 Sanna Amanikare Village, Kasaba Hobli, Devanahalli, Bengaluru-562110, Karnataka
New paradigms in the science of care.
Our Services
Our robust portfolio of medicines in Cardiac, Diabetic, Gynaec, Pediatrics, General and host of Wellness products and Nutraceuticals is a testimony to our undeterred commitment to be relevant to the contemporary lifestyle.
Our Team

Rabinlal Kuttiyil
Chairman

M.M. Maitra
Marketing Director

Subhisha P
Chairperson

Renjith Madhav
Director
Our Product Quality Certifications
You need a help? We Have Answers! Call Us!
With access to 24 hour emergency assistance, It’s so important you can continue to help others.
News and Events